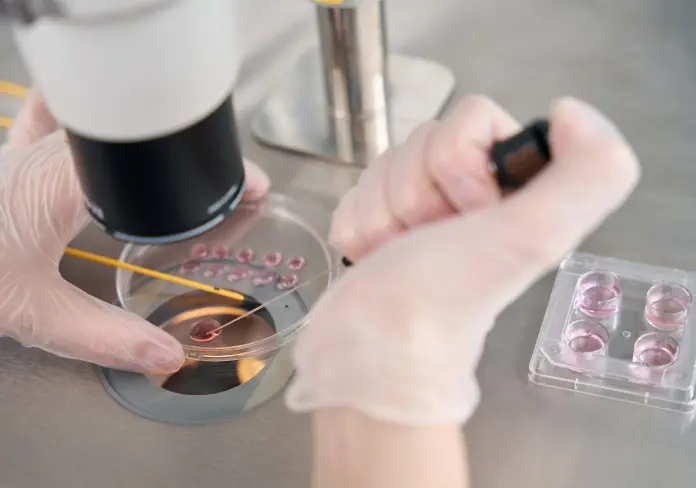

Duration of Stay in Athens
for IVF Treatment


- Initial Consultations and Testing: Upon arrival in Athens, couples will need to undergo a series of medical tests and consultations with the fertility specialist. This typically includes hormonal assessments, ultrasounds, and a semen analysis. If the clinic has already reviewed medical records before the trip, this process can be expedited.
- Time Required: Generally, this phase takes 1-2 days. Couples may have the option to complete some of the testing at home prior to arrival to shorten this period.
- Ovarian Stimulation: Once the initial tests are done, the ovarian stimulation phase begins. This involves daily or every-other-day hormone injections to stimulate egg production, along with monitoring by ultrasound and blood tests to ensure the ovaries are responding well.
- Time Required: This phase usually lasts around 10 to 14 days, depending on how the ovaries respond to the medication. During this time, the couple will have regular appointments with the clinic to monitor progress.

- Egg Retrieval: Once the eggs have matured, a minor surgical procedure is performed to retrieve them. This process is quick, typically lasting 30 minutes to an hour, and is done under light sedation. The sperm sample is collected or prepared around the same time.
- Fertilization in the Lab: After retrieval, the eggs are fertilized with the sperm in the laboratory (either through traditional IVF or ICSI), and the development of embryos begins.
- Time Required: This stage takes 1-2 days. The couple may need a rest day after the egg retrieval procedure, but it is generally well-tolerated.
- Embryo Culture: After fertilization, the embryos are cultured in the lab for 3 to 5 days to reach the blastocyst stage. The clinic will monitor the development of the embryos during this time.
- Embryo Transfer: The best-quality embryo(s) are transferred into the uterus, a quick and painless procedure. The couple may choose to stay in Athens a few extra days to ensure that the woman rests after the transfer, although this is not strictly necessary.
- Time Required: Embryo culture takes 3 to 5 days, followed by the transfer, which is done on the same day.


- Rest After Transfer: While medical advice often suggests that women can resume normal activities soon after the embryo transfer, some couples prefer to stay in Athens for a few days after the procedure to rest and minimize stress before traveling home.
- Initial Pregnancy Monitoring: In some cases, the clinic may suggest a blood test or ultrasound within the first few days after the transfer to check for early signs of pregnancy. Alternatively, couples can return home and take a blood test about 10 days after the transfer.
- Time Required: Couples often choose to stay for an additional 3 to 5 days after the embryo transfer, especially if they want to combine the treatment with a vacation.
- Freezing of Embryos: If there are surplus embryos, they can be frozen for future use. This process does not extend the stay but might be a topic to discuss during follow-up consultations.
- Follow-Up: After returning home, the couple will stay in touch with the clinic for follow-up appointments and pregnancy monitoring. If pregnancy occurs, additional support or guidance may be provided remotely.



